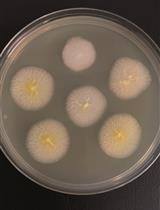
Genomic Edition of <em>Ashbya gossypii</em> Using One-vector CRISPR/Cas9

- Submit a Protocol
- Receive Our Alerts
- Log in
- /
- Sign up
- My Bio Page
- Edit My Profile
- Change Password
- Log Out
- EN
- EN - English
- CN - 中文
- Protocols
- Articles and Issues
- For Authors
- About
- Become a Reviewer
- EN - English
- CN - 中文
- Home
- Protocols
- Articles and Issues
- For Authors
- About
- Become a Reviewer
Single-step Marker Switching in Schizosaccharomyces pombe Using a Lithium Acetate Transformation Protocol
Published: Vol 6, Iss 24, Dec 20, 2016 DOI: 10.21769/BioProtoc.2075 Views: 9646
Reviewed by: Yanjie LiBelen SanzAnonymous reviewer(s)

Protocol Collections
Comprehensive collections of detailed, peer-reviewed protocols focusing on specific topics
Related protocols

Development of an Efficient Transformation System for Halotolerant Yeast Debaryomyces hansenii CBS767
Anu P. Minhas and Dipanwita Biswas
Sep 5, 2019 4250 Views

Isolation and Characterization of Live Yeast Cells from Ancient Clay Vessels
Tzemach Aouizerat [...] Ronen Hazan
Jan 5, 2020 6422 Views
Genomic Edition of Ashbya gossypii Using One-vector CRISPR/Cas9
Gloria Muñoz-Fernández [...] José Luis Revuelta
Jun 20, 2020 4827 Views
Abstract
The ability to utilize different selectable markers for tagging or mutating multiple genes in Schizosaccharomyces pombe is hampered by the historical use of only two selectable markers, ura4+ and kanMX6; the latter conferring resistance to the antibiotic G418 (geneticin). More markers have been described recently, but introducing these into yeast cells often requires strain construction from scratch. To overcome this problem we and other groups have created transformation cassettes with flanking homologies to ura4+ and kanMX6 which enable an efficient and time-saving way to exchange markers in existing mutated or tagged fission yeast strains.
Here, we present a protocol for single-step marker switching by lithium acetate transformation in fission yeast, Schizosaccharomyces pombe. In the following we describe how to swap the ura4+ marker to a kanMX6, natMX4, or hphMX4 marker, which provide resistance against the antibiotics G418, nourseothricin (clonNAT) or hygromycin B, respectively. We also detail how to exchange any of the MX markers for nutritional markers, such as arg3+, his3+, leu1+ and ura4+.
Background
This single-step marker swap protocol for Schizosaccharomyces pombe allows for any tagged or mutated gene marked with an MX-type antibiotic marker to be swapped for a nutritional marker (cassettes containing the arg3+, his3+, leu1+, and ura4+ have been constructed) and to exchange genetic ura4+-markers for any MX-type antibiotic resistance marker (kanMX, natMX, and hphMX constructs have been tested for this study) (Lorenz et al., 2015a). Previously, this kind of approach was only feasible for MX-type antibiotic resistance markers (Sato et al., 2005; Hentges et al., 2005). Exchanging antibiotic resistance markers for each other already represented a basic set of useful genetic tools, the ura4+-to-MX as well as the arg3MX4, his3MX4, leu1MX4, and ura4MX4 marker swap cassettes expand this genetic toolbox for tagging and mutating genes in fission yeast (Lorenz et al., 2015a). The lithium acetate transformation protocol itself was described previously (Keeney and Boeke, 1994) and recently suggested modifications (http://listserver.ebi.ac.uk/pipermail/pombelist/2014/004012.html) were incorporated to provide a highly efficient procedure. Streamlining Schizosaccharomyces pombe strain construction in this way is time-saving and, therefore, will prove useful for fission yeast researchers.
Materials and Reagents
- Conical tubes:
15 ml (Greiner Bio One, catalog number: 188261 )
50 ml (Greiner Bio One, catalog number: 227261 ) - 1.5 ml centrifuge tubes (Greiner Bio One, catalog number: 616201 )
- 0.2 ml flat-cap PCR tubes (Corning, Axygen®, catalog number: PCR-02-C )
- Petri dishes (Greiner Bio One, catalog number: 633185 )
- BD Plastipak 10 ml syringes (BD, catalog number: 302188 )
- Millex-GP 33 mm diameter sterile syringe filter units (Polyethersulfone [PES] membrane, pore size: 0.22 µm) (EMD Millipore, catalog number: SLGPO33RS )
- Appropriate Schizosaccharomyces pombe strains: for a marker swap the strain must already carry a mutant or tagged gene marked with either an ura4+ or MX-type marker, such as kanMX, natMX, or hphMX (Bähler et al., 1998; Goldstein and McCusker, 1999). When introducing arg3MX4, his3MX4, leu1MX4, or ura4MX4 into a strain, this strain needs to be mutated for the respective gene at its original locus, e.g., arg3-D4 (Waddell and Jenkins, 1995), his3-D1 (Burke and Gould, 1994), leu1-32 (Keeney and Boeke, 1994), or ura4-D18 (Grimm et al., 1988).
- Plasmids: pALo120 (FYP2884), pALo121 (FYP2885), pALo122 (FYP2886), pFA6a-arg3MX4 (FYP2890), pFA6a-his3MX4 (FYP2891), pFA6a-leu1MX4 (FYP2892), and pFA6a-ura4MX4 (FYP2893) (Lorenz, 2015a and 2015b); plasmid can be obtained from the National BioResource Project (NRBP) of MEXT, Japan (please refer to FYP numbers when ordering).
- Sonicated salmon sperm DNA (Sigma-Aldrich, catalog number: 31149 )
- Agarose, molecular grade (Bioline, catalog number: BIO-41026 )
- Q5 high fidelity DNA polymerase (New England Biolabs, catalog number: M0491 )
- 5x Q5 reaction buffer (accessory part of Q5 high fidelity polymerase) (New England Biolabs, catalog number: M0491 )
- 10 mM dNTPs (Thermo Fisher Scientific, Thermo ScientificTM, catalog number: R0191 )
- 10 µM oligonucleotides (to be used as primers in PCR reactions) (Sigma-Aldrich, USA)
- MilliQ H2O drawn from a MilliQ Advantage A10 system (EMD Millipore, catalog number: Z00Q0V0WW )
- CutSmart buffer (accessory part of restriction enzymes, can also be ordered separately under New England Biolabs, catalog number: B2704 )
- Restriction enzymes:
XbaI restriction enzyme (New England Biolabs, catalog number: R0145 )
BamHI-HF restriction enzyme (New England Biolabs, catalog number: R3136 )
EcoRI-HF restriction enzyme (New England Biolabs, catalog number: R3101 )
PvuII-HF restriction enzyme (New England Biolabs, catalog number: R3151 )
SacI-HF restriction enzyme (New England Biolabs, catalog number: R3156 ) - Di-methyl sulfoxide (DMSO) (Sigma-Aldrich, catalog number: D8418 )
- Ethylenediaminetetraacetic acid (EDTA) (Thermo Fisher Scientific, Fisher Scientific, catalog number: 10526383 )
- Sodium hydroxide (NaOH) pellets (anhydrous) (Sigma-Aldrich, catalog number: S8045 )
- Tris(hydroxymethyl)aminomethane (VWR, catalog number: 103156X )
- Glacial (100%) acetic acid (VWR, catalog number: 20104.334 )
- Yeast extract, microgranulated (ForMediumTM, catalog number: YEM02 )
- Glucose anhydrous (Thermo Fisher Scientific, Fisher Scientific, catalog number: 10373242 )
- Adenine (Sigma-Aldrich, catalog number: A5665 )
- Uracil (ForMediumTM, catalog number: DOCO212 )
- Leucine (ForMediumTM, catalog number: DOCO156 )
- Lysine (Sigma-Aldrich, catalog number: L8662 )
- Histidine (Sigma-Aldrich, catalog number: H5659 )
- Arginine (Sigma-Aldrich, catalog number: A6969 )
- Agar granulated (ForMediumTM, catalog number: AGR10 )
- G418 disulfate (ForMediumTM, product number: G4181 )
- Nourseothricin-dihydrogen sulfate (clonNAT) (Werner BioAgents, catalog number: clonNAT)
- Hygromycin B (ForMediumTM, catalog number: HYG1000 )
- Yeast nitrogen base without amino acids and without ammonium sulfate (ForMediumTM, catalog number: CYN0502 )
- L-glutamic acid monosodium salt hydrate (sodium glutamate) (Sigma-Aldrich, catalog number: G5889 )
- 5 N hydrochloric acid (HCl) (VWR, catalog number: 30018.320 )
- Lithium acetate (Sigma-Aldrich, catalog number: L4158 )
- Polyethylene glycol (PEG) MW 3,350 (Sigma-Aldrich, catalog number: P4338 )
- DNA molecular weight marker, HyperLadderTM 1 kb (Bioline, catalog number: BIO-33025 )
- 0.5 M EDTA (pH 8.0) (see Recipes)
- 50x TAE gel electrophoresis buffer (see Recipes)
- YES (Yeast extract supplemented) broth (see Recipes)
- YES plates (see Recipes)
- Concentration of antibiotics in YES media (see Recipes)
- YNG (Yeast nitrogen base glutamate) plates (see Recipes)
- 1 M Tris/HCl (pH 7.5) (see Recipes)
- 1 M LiAc (pH 7.5) (see Recipes)
- 10x TE (pH 7.5) (see Recipes)
- LiAc/TE (see Recipes)
- 40% PEG (see Recipes)
Equipment
- Erlenmeyer glass flasks for culturing yeast (DURAN Group, catalog number: 2177144 )
- Infors HT multitron standard shaking incubator (Infors, model: Multitron Standard )
- Static incubator (Gallenkamp forced air incubator) (Weiss Technik UK)
- Water baths (Grant Instruments, catalog number: JBN5 )
- Eppendorf microcentrifuge (Eppendorf, model: 5424R )
- MJ Research PTC-100 programmable thermal cycler
- Nucleic acid gel electrophoresis system consisting of a gel electrophoresis chamber with a 7 x 10 cm tray (Bio-Rad Laboratories, model: Mini-Sub® Cell GT ) and a power supply (Bio-Rad Laboratories, model: PowerPacTM Basic Power Supply )
- NanoDrop 2000c UV/Vis-spectrophotometer (Thermo Fisher Scientific, Thermo ScientificTM, model: ND-2000C )
- Sigma 4-16K centrifuge (Sigma Laborzentrifugen, model: Sigma 4-16K )
- Haemocytometer, type Neubauer improved (Marienfeld-Superior, catalog number: 0630010 )
- Leica DM500 microscope (Leica Microsystems, model: Leica DM500 )
- Classic Media 12 L autoclave (Prestige Medical, model: 210048 )
Procedure
- Generation of marker swap cassettes for transformation
Marker swap cassettes to be used in the lithium acetate protocol below can be generated by two alternative means; by PCR amplification from or by restriction endonuclease digestion of the plasmids previously described in Lorenz (2015a and 2015b) (see below). Using appropriate modifications, this protocol can also be applied to constructs described elsewhere (Sato et al., 2005; Hentges et al., 2005; Gadaleta et al., 2013; Chen et al., 2015). After the PCR or restriction digest run 1/20 volume of each reaction on a 0.8% agarose gel in 1x TAE at 80 V for 45 min to verify that the reaction has worked properly (band sizes to be expected for each reaction are detailed below). The remainder of the PCR reaction or restriction is stopped by the addition of 2 μl of 0.5 M EDTA (pH 8.0). DNA concentration is measured on a NanoDrop 2000c UV/Vis-spectrophotometer, and an appropriate volume (maximum 20 μl) to result in 1-5 μg of cassette DNA is used for each transformation.- ura4+ marker swap cassette amplification
- A 50 μl PCR reaction contains:
100 ng of DNA from plasmid pALo120, pALo121, or pALo122 (Lorenz, 2015a and 2015b) to create cassettes by PCR for swapping an ura4+ marker to a kanMX6, natMX4, or hphMX4 marker, respectively.
10 μl 5x Q5 reaction buffer
200 μM dNTPs
500 nM each of AL1forw (5’-agctacaaatcccactgg-3’) and AL1rev (5’-gtgatattgacgaaactttttg-3’) oligonucleotides as primers
1 U Q5 high-fidelity DNA polymerase
Make up to 50 μl by adding the appropriate amount of sterile MilliQ water (see Note 1). - Use the following PCR programme:
30 sec at 98 °C
35 x (10 sec at 98 °C, 20 sec at 55 °C, 85 sec at 72 °C)
120 sec at 72 °C - Expected band sizes for transformation cassettes:
pALo120 (ura4+-to-kanMX6 swapping cassette): 1.97 kb
pALo121 (ura4+-to-natMX4 swapping cassette): 1.74 kb
pALo122 (ura4+-to-hphMX4 swapping cassette): 2.2 kb
- A 50 μl PCR reaction contains:
- Restriction digest to liberate ura4+ marker swap cassettes
- A 20 μl reaction contains:
12 μg of DNA from plasmid pALo120, pALo121, or pALo122 (this will result in ~5 μg of marker swap cassette DNA) (Lorenz, 2015a and 2015b).
2 µl CutSmart buffer
2 µl XbaI restriction enzyme
Make up to 20 μl by adding the appropriate amount of sterile MilliQ water (see Note 1). - Incubate reaction at 37 °C for 1 h.
- Expected band sizes after restriction digest:
pALo120: 1.98 kb (cassette) and 2.64 kb (vector backbone)
pALo121: 1.75 kb (cassette) and 2.64 kb (vector backbone)
pALo122: 2.2 kb (cassette) and 2.64 kb (vector backbone)
- A 20 μl reaction contains:
- MX marker swap cassette amplification
- A 50 μl PCR reaction contains:
100 ng of DNA from plasmid pFA6a-arg3MX4, pFA6a-his3MX4, pFA6a-leu1MX4, or pFA6a-ura4MX4 (Lorenz, 2015a and 2015b) to create cassettes by PCR for swapping any MX-type marker to a arg3+, his3+, leu1+, or ura4+ marker, respectively.
10 μl 5x Q5 reaction buffer
200 μM dNTPs
500 nM each of AL2forw (5’-gtttagcttgcctcgtccc-3’) and AL2rev (5’-gatggcggcgttagtatcg-3’) oligonucleotides as primers
1 U Q5 high-fidelity DNA polymerase
Make up to 50 μl by adding the appropriate amount of sterile MilliQ water (see Note 1). - Use the following PCR programme:
30 sec at 98 °C
35 x (10 sec at 98 °C, 20 sec at 64 °C, 90 sec at 72 °C)
120 sec at 72 °C - Expected band sizes for transformation cassettes:
pFA6a-arg3MX4: 2.54 kb
pFA6a-his3MX4: 2.65 kb
pFA6a-leu1MX4: 2.19 kb
pFA6a-ura4MX4: 2.39 kb
- A 50 μl PCR reaction contains:
- Restriction digest to liberate arg3MX4, leu1MX4, and ura4MX4 marker swap cassettes
- A 20 μl reaction contains:
10 μg of DNA from plasmid pFA6a-arg3MX4, pFA6a-leu1MX4, or pFA6a-ura4MX4 (this will result in ~5 μg of marker swap cassette DNA) (Lorenz, 2015a and 2015b).
2 µl CutSmart buffer
1 µl BamHI-HF restriction enzyme
1 µl EcoRI-HF restriction enzyme
Make up to 20 μl by adding the appropriate amount of sterile MilliQ water (see Note 1). - Incubate reaction at 37 °C for 1 h.
- Expected band sizes after restriction digest:
pFA6a-arg3MX4: 2.6 kb (cassette) and 2.47 kb (vector backbone)
pFA6a-leu1MX4: 2.24 kb (cassette) and 2.47 kb (vector backbone)
pFA6a-ura4MX4: 2.44 kb (cassette) and 2.47 kb (vector backbone)
- A 20 μl reaction contains:
- Restriction digest to liberate the his3MX4 marker swap cassette
- A 20 μl reaction contains:
10 μg of DNA from plasmid pFA6a-his3MX4 (this will result in ~5 μg of marker swap cassette DNA) (Lorenz, 2015a and 2015b).
2 µl CutSmart buffer
1 µl PvuII-HF restriction enzyme
1 µl SacI-HF restriction enzyme
Make up to 20 μl by adding the appropriate amount of sterile MilliQ water (see Note 1). - Incubate reaction at 37 °C for 1 h.
- Expected band sizes after restriction digest:
pFA6a-his3MX4: 2.72 kb (cassette) and 2.44 kb (vector backbone)
- A 20 μl reaction contains:
- ura4+ marker swap cassette amplification
- Lithium acetate transformation
- Grow 100 ml of yeast cells from the strain(s) to be transformed in YES broth in a shaking incubator at 30 °C to a density of ~1 x 107 cells/ml (count with haemocytometer to establish density) (see Notes 2 and 3).
- Harvest by centrifugation (in two 50 ml conical tubes) at 1,900 x g for 3 min at 20 °C.
- Resuspend cells in 25 ml of sterile MilliQ water, and combine into one 50 ml conical tube.
- Harvest by centrifugation at 1,900 x g for 3 min at 20 °C.
- Resuspend cells in 5 ml LiAc/TE (see Recipes), centrifuge at 1,900 x g for 3 min at 20 °C.
- Resuspend cells in 1 ml LiAc/TE and transfer to 1.5 ml centrifuge tube.
- Centrifuge at 2,300 x g for 1 min at room temperature. Discard supernatant and resuspend cells at ~3 x 109 cells/ml in LiAc/TE (normally 300 µl, if starter culture was 100 ml of 1 x 107 cells/ml).
- To 100 µl of cells add 2 µl of sonicated salmon sperm DNA (10 mg/ml) and the DNA to transform (1-5 µg in a maximum volume of 20 µl). Mix well by carefully pipetting up and down.
- Incubate at room temperature for 10 min.
- Add 260 µl 40% PEG (see Recipes and Note 4) and incubate for 2-6 h at 30 °C. Mix well by carefully pipetting up and down.
- Add 43 µl DMSO (dimethyl sulfoxide), mix well by inverting the tube five times, and heat shock for 5 min at 42 °C (see Note 5).
- Plate suspension by evenly spreading onto 3 YES plates (~135 µl on each plate) without selection (see Recipes).
- After 24-48 h incubation at 30 °C, replica-plate these plates onto selective plates; either onto YES containing the corresponding antibiotic, or onto YNG lacking the corresponding supplement.
- Allow the selective plates to grow at 30 °C for several days until single colonies reach a diameter of 3-4 mm.
- Patch at least 20 colonies onto a fresh selective plate and incubate 24-48 h.
- Replica-plate onto a fresh selective plate and onto a plate selecting for the original marker, to ensure that the marker swap is correct (e.g., if the original strain was ura4+ and pALo120 was used to swap to kanMX6, the resulting strain must be resistant to G418 and unable to grow on media lacking uracil).
- Grow 100 ml of yeast cells from the strain(s) to be transformed in YES broth in a shaking incubator at 30 °C to a density of ~1 x 107 cells/ml (count with haemocytometer to establish density) (see Notes 2 and 3).
Data analysis
The critical step of the single-step marker swap procedure is to confirm that the markers have been truly exchanged in a transformant, i.e., that the new marker is correctly integrated at the target site, thereby removing the original marker. It is known that marker integration at its intended target site is not perfectly efficient in Schizosaccharomyces pombe, and a wide range of correct integration frequencies have been reported (Bähler et al., 1998; Sato et al., 2005). Correct integration is influenced by several parameters, including the chromatin status of the genomic site and length of sequence homologies flanking the marker cassettes. In the presented single-step marker swap cassettes flanking sequence homologies are between 200 and 400 bps, which is longer than the required minimum 80 bps (Bähler et al., 1998), but not long enough to enable 100% correct targeting in all cases. Swapping the ura4+ marker to any of the antibiotic MX markers occurred at frequencies between 22.9-100%. The correct integration efficiency of swapping an MX marker to a nutritional marker was tested at the meiotic gene hop1; this is more challenging due to the closed chromatin state at meiotic open reading frames (Bähler et al., 1998). Therefore, the frequency of exchanging a kanMX6-marker deleting hop1 with a nutritional marker was lower and varied between 15.3-36.6% (Lorenz, 2015a).
Notes
- When pipetting a PCR reaction or restriction digest, always start with the MilliQ water, add the buffer, then all other components, and finally the enzyme(s). Working from these protocols, it is important to calculate the amount of water required before one sets up the reaction.
- For the transformation protocol use yeast cells streaked onto the appropriate plate not longer than 7 days beforehand. Always check the genotype of yeast strains carefully before usage!
- It is crucial to grow the fission yeast cells to late logarithmic phase (~1 x 107 cells/ml) to achieve the most efficient transformation frequency. Growing cells to higher density will result in drastically reduced numbers of transformants, because cells enter stationary phase and develop a thicker cell wall (i.e., do not grow cells to higher than ~1 x 107 cells/ml and dilute).
- 40% PEG (see Recipes) needs to be prepared freshly on the day when the transformation is performed.
- The duration and temperatureof the heat shock (step B11) is critical!
Recipes
- 0.5 M EDTA (pH 8.0) (1 L)
186.1 g ethylenediaminetetraacetic acid (EDTA)
Add 800 ml MilliQ water
Adjust pH to 8.0 by adding NaOH pellets (solution will only become clear when pH > 7)
Make up with MilliQ water to volume
Sterilize by autoclaving - 50x TAE gel electrophoresis buffer (1 L)
242 g Tris(hydroxymethyl)aminomethane
57.1 ml glacial acetic acid
100 ml 0.5 M EDTA (pH 8.0)
Make up with MilliQ water to volume
Sterilize by autoclaving
Use as 1x TAE by diluting 1:50 in MilliQ water - YES (Yeast extract supplemented) broth (1 L)
5 g yeast extract, microgranulated
30 g glucose anhydrous
250 mg adenine
250 mg uracil
250 mg leucine
250 mg lysine
250 mg histidine
250 mg arginine
Make up with MilliQ water to volume
Sterilize by autoclaving - YES plates (1 L, makes about 40 plates)
As YES broth
20 g agar granulated
Sterilize by autoclaving - Concentration of antibiotics in YES media (per 1 L)
Note: Antibiotics are added to YES agar cooled down to 55 °C after autoclaving!
200 mg G418 disulfate
200 mg nourseothricin-dihydrogen sulfate (clonNAT)
400 mg hygromycin B - YNG (Yeast nitrogen base glutamate) plates (1 L, makes about 40 plates)
1.9 g yeast nitrogen base (without amino acids and without ammonium sulfate)
3.7 g L-glutamic acid monosodium salt hydrate (sodium glutamate)
30 g glucose anhydrous
20 g agar granulated
75 mg adenine
75 mg uracil
75 mg leucine
75 mg lysine
75 mg histidine
75 mg arginine
Make up with MilliQ water to volume
Sterilize by autoclaving - 1 M Tris/HCl (pH 7.5) (1 L)
121.1 g Tris(hydroxymethyl)aminomethane
Add 800 ml MilliQ water
Adjust pH to 7.5 by adding 5 N HCl
Make up with MilliQ water to volume
Sterilize by autoclaving - 1 M LiAc (pH 7.5; 100 ml)
20.4 g lithium acetate
Add 70 ml MilliQ water
Adjust pH to 7.5 with acetic acid, if necessary
Make up with MilliQ water to volume
Sterilize by autoclaving - 10x TE (pH 7.5; 100 ml)
2 ml 0.5 M EDTA (pH 8.0) (final concentration 0.01 M)
10 ml 1 M Tris/HCl (pH 7.5) (final concentration 0.1 M)
Make up with MilliQ water to volume
Sterilize by autoclaving - LiAc/TE (10 ml)
1 ml 1 M LiAc (pH 7.5)
1 ml 10x TE (pH 7.5) (0.1 M Tris, 0.01 M EDTA)
8 ml sterile MilliQ water - 40% PEG (10 ml)
4 g PEG (polyethylene glycol) MW 3,350
1 ml 1 M LiAc (pH 7.5)
1 ml 10x TE (0.1 M Tris, 0.01 M EDTA)
4 ml sterile MilliQ water
Dissolve PEG completely (incubate at 37 °C for a few minutes, if necessary).
Make up to 10 ml
Filter sterilize
Acknowledgments
We acknowledge funding from the Biotechnology and Biological Sciences Research Council UK (BBSRC, Doctoral Training Grant BB/FO16964/1) and the College of Life Science and Medicine, University of Aberdeen, UK.
References
- Bähler, J., Wu, J. Q., Longtine, M. S., Shah, N. G., McKenzie, A., 3rd, Steever, A. B., Wach, A., Philippsen, P. and Pringle, J. R. (1998). Heterologous modules for efficient and versatile PCR-based gene targeting in Schizosaccharomyces pombe. Yeast 14(10): 943-951.
- Burke, J. D. and Gould, K. L. (1994). Molecular cloning and characterization of the Schizosaccharomyces pombe his3 gene for use as a selectable marker. Mol Gen Genet 242(2): 169-176.
- Chen, Y., Chen, L., An, K., Wang, Y. and Jin, Q. (2015). A vector system for efficient and economical switching of a ura4+ module to three commonly used antibiotic marker cassettes in Schizosaccharomyces pombe. Yeast 32(11): 671-682.
- Gadaleta, M. C., Iwasaki, O., Noguchi, C., Noma, K. and Noguchi, E. (2013). New vectors for epitope tagging and gene disruption in Schizosaccharomyces pombe. Biotechniques 55(5): 257-263.
- Grimm, C., Kohli, J., Murray, J. and Maundrell, K. (1988). Genetic engineering of Schizosaccharomyces pombe: a system for gene disruption and replacement using the ura4 gene as a selectable marker. Mol Gen Genet 215(1): 81-86.
- Goldstein, A. L. and McCusker, J. H. (1999). Three new dominant drug resistance cassettes for gene disruption in Saccharomyces cerevisiae. Yeast 15(14): 1541-1553.
- Hentges, P., Van Driessche, B., Tafforeau, L., Vandenhaute, J. and Carr, A. M. (2005). Three novel antibiotic marker cassettes for gene disruption and marker switching in Schizosaccharomyces pombe. Yeast 22(13): 1013-1019.
- Keeney, J. B. and Boeke, J. D. (1994). Efficient targeted integration at leu1-32 and ura4-294 in Schizosaccharomyces pombe. Genetics 136(3): 849-856.
- Lorenz, A. (2015a). New cassettes for single-step drug resistance and prototrophic marker switching in fission yeast. Yeast 32(12): 703-710.
- Lorenz, A. (2015b). Plasmid sequences: New cassettes for single-step drug-resistance and prototrophic marker switching in fission yeast. figshare, 10.6084/m9.figshare.1468419.
- Sato, M., Dhut, S. and Toda, T. (2005). New drug-resistant cassettes for gene disruption and epitope tagging in Schizosaccharomyces pombe. Yeast 22(7): 583-591.
- Waddell, S. and Jenkins, J. R. (1995). arg3+, a new selection marker system for schizosaccharomyces pombe: application of ura4+ as a removable integration marker. Nucleic Acids Res 23(10): 1836-1837.
Article Information
Copyright
© 2016 The Authors; exclusive licensee Bio-protocol LLC.
How to cite
Brown, S. D. and Lorenz, A. (2016). Single-step Marker Switching in Schizosaccharomyces pombe Using a Lithium Acetate Transformation Protocol. Bio-protocol 6(24): e2075. DOI: 10.21769/BioProtoc.2075.
Category
Microbiology > Microbial genetics > Gene mapping and cloning
Microbiology > Microbial genetics > Transformation
Molecular Biology > DNA > DNA recombination
Do you have any questions about this protocol?
Post your question to gather feedback from the community. We will also invite the authors of this article to respond.
Share
Bluesky
X
Copy link











